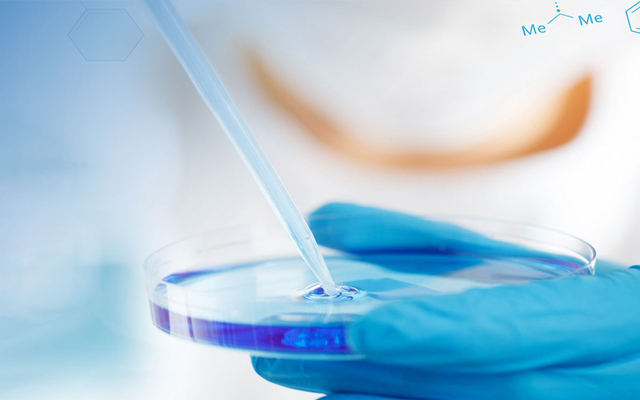
北京金奧利維科技發展有限公司

北京金奧利維科技發展有限公司成立于2000年,是集醫藥、農藥中間體的技術開發和銷售于一體的企業。公司主要供應有機氟,有機硼酸,吡啶類、吲哚類衍生物、手性試劑等醫藥與農藥中間體等化工產品。
盤錦生產基地位于遼寧盤錦精細化工園區,該基地的生產車間配備300L-3000L搪瓷反應釜數臺、并配套精餾塔、離心機、烘干箱等常規設備,可滿足-20度至220度的工藝需求。
盤錦生產基地具有完善的質量管理體系,并通過ISO9001質量體系認證。質檢部配備液相色譜(HPLC),氣相色譜(GC),卡爾費休水分滴定儀、熔點儀等常規檢測設備,可保證從原料采購,生產中控,產品發貨,實行全過程質量控制和管理。
我們的宗旨是運用敬業的精神,向廣大用戶提供好的產品和技術服務。我們珍惜每一次與您合作的機會,歡迎海內外客商與我公司洽談合作!

郵箱: jalw@goldolive.com
網址: www_goldolive_com.zonetec.com.cn
北京金奧利維科技發展有限公司 版權所有(C)2021 網絡支持 中國化工網 全球化工網 生意寶 網盛建站 著作權聲明 京ICP備18032018號